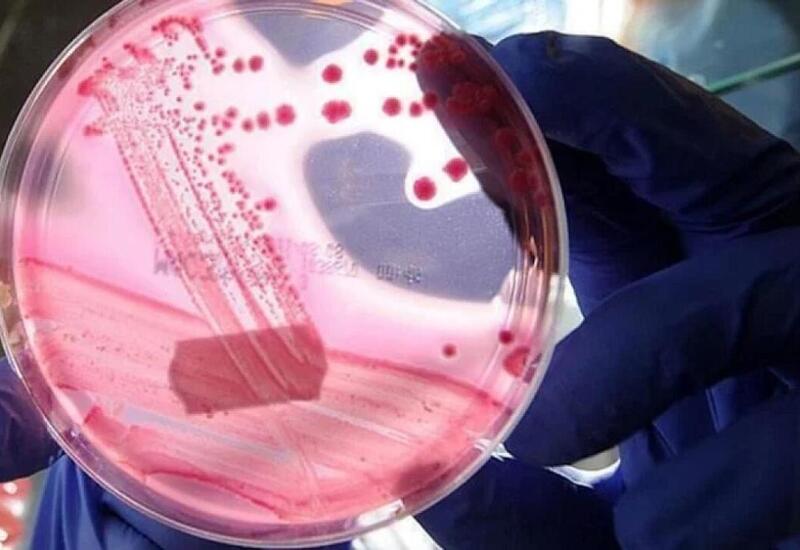

Səhiyyə Nazirliyinin açıqlamasına əsasən, prostat xərçəngi kişilər arasında ağciyər xərçəngindən sonra ən çox müşahidə edilən ikinci onkoloji xəstəlikdir.
Day.Az Milli.Az-a istinadən xəbər verir ki, İzmir Katip Çələbi Universiteti Atatürk Təhsil və Araşdırma Xəstəxanasının Urologiya şöbəsinin müdiri Prof. Dr. Yiğit Akın bu xəstəliyin kişilər arasında geniş yayıldığını vurğulayıb. Onun sözlərinə görə, hər 100 min kişidən 2-3 nəfərində prostat xərçəngi aşkarlanır.
Prof. Akın bildirib ki, xəstəliyin yaranma səbəbləri tam müəyyən edilməsə də, irsi meyillilik, ətraf mühit faktorları və qidalanma vərdişləri əsas rol oynayır. Ailəsində prostat xərçəngi diaqnozu qoyulmuş kişilərdə riskin təxminən dörd dəfə yüksək olduğunu qeyd edən həkim, bu səbəbdən həmin şəxslərə 40 yaşdan, digər kişilərə isə 45 yaşdan etibarən hər il uroloji müayinədən keçməyi tövsiyə edib.
Mütəxəssisin sözlərinə görə, prostat xərçəngi ilk mərhələlərdə heç bir əlamət göstərmədən inkişaf edə bilər:
"İldə bir dəfə uroloqa müraciət edib PSA testindən keçmək çox vacibdir. Vaxtında aparılan müayinələr həyatı xilas edə bilər," - deyə Prof. Akın bildirib.
O əlavə edib ki, erkən diaqnoz qoyulduğu halda ən effektiv müalicə üsulu cərrahi əməliyyatdır. Klinikalarında laparoskopik üsulla həyata keçirilən əməliyyatlar sayəsində minlərlə xəstənin uğurla sağaldığını qeyd edib.
Prof. Akın, həmçinin 45 yaşdan yuxarı kişilərə sağlam qidalanma rejimi, az yağlı pəhriz, tərəvəzlərlə zəngin menyu və gündə ən az 30 dəqiqəlik yüngül fiziki fəaliyyət sayəsində prostat xərçəngi riskini azaltmağı məsləhət görüb.